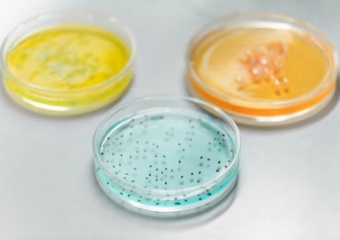

Inovacije
Trenutna tehnologija fermentacije temelji na modrosti starodavnih časov. Zato uporabljamo samo varne in znane mikroorganizme, da bioaktivnost usmerjeno spravimo v nadzorovano in stabilno stopnjo, predvsem pa z najsodobnejšimi sodobnimi proizvodnimi zmogljivostmi in upravljanjem.
Inovatorstvo

Zakaj izbrati FermtekTM

10 let neprekinjenih izkušenj s fermentacijo

Ogromna banka sort in registriranih sevov

Dve posamezni proizvodni liniji za fermentacijo in ekstrakcijo

Napredni laboratoriji, ki uporabljajo najsodobnejšo opremo

Sistemi zagotavljanja kakovosti (kot so cGMP, HACCP, FSSC22000 itd.)

Popolnoma nadzorovan proces fermentacije in ekstrakcije
Kako FermtekTMZadeve

Močna platforma za raziskave in razvoj ter tehnična podpora

Vse večja zaskrbljenost glede varnosti hrane

Zahteva po znižanju stroškov

Trajnostni razvoj ekologije
Moč raziskav in razvoja
HSF se osredotoča na model neodvisnih raziskav in razvoja, ki ga dopolnjuje razvoj sodelovanja. Z univerzo Shaanxi Normal je ustanovil skupni mikrobiološki laboratorij in ima zdaj štiri laboratorije.
1.Mikrobni raziskovalni laboratoriji: presejanje sevov, mutageneza, genski inženiring, stimulacija potenciala sevov.
2. Laboratorij za biotransformacijo: preučevanje metabolitov seva in encimskih aktivnosti za izboljšanje izkoristka produkta.
3. Fermentacijski laboratorij: optimizacija fermentacijskih pogojev, fermentacija korak za korakom širitev primerne proizvodnje.
4. Laboratorij za ekstrakcijo in ločevanje: preučite posebne pogoje ekstrakcije na podlagi značilnosti izdelka, da izboljšate donos in zmanjšate stroške.

Prednosti HSF FermtekTM

Prednost ena:
napreden koncept upravljanja in zvočni sistem.
Imamo mednarodni napredni koncept upravljanja fermentacijske delavnice in smo zgradili strog sistem vodenja kakovosti (cGMP, ISO22000, ISO9001, Halal, Kosher, SC Certification). Zagotavljanje aseptičnega okolja, kakovosti izdelkov in stabilnosti med proizvodnimi serijami za izpolnjevanje zahtev strank glede varnosti in visoke kakovosti izdelkov.
Druga prednost:
napredna naprava za fermentacijo z natančnim nadzorom parametrov fermentacije.
HSF ima v lasti mednarodno napredno opremo za fermentacijo, opremo za membransko filtracijo, opremo za sušenje z zamrzovanjem in popolnoma avtomatsko nadzorno opremo. Natančno nadzorujte kisik, temperaturo, pH in metodo dopolnjevanja med postopkom fermentacije, da izkoristite največji potencial seva.
Tretja prednost:
samorazviti patentirani sevi in pogoji gojenja.
Večina fermentacijskih sevov HSF izvira iz samorazvitih patentiranih sevov. HSF ima vodilno visoko prepustnost in visoke stopnje pretvorbe. V skladu z edinstveno naravo različnih sevov optimizirajte pogoje fermentacije, razvijte naravne in poceni gojišča, zmanjšajte stroške in izboljšajte konkurenčnost industrije.
Kakovost in akreditacija
Potrdilo nas je veliko revizij na objektih in dokumentaciji svetovno znanih blagovnih znamk. Registriran SEDEX in Ecovadis z visoko oceno, HSF ohranja zdravo trajnost in družbeno odgovornost, s svojo zavezanostjo visokokakovostnim standardom upravljanja, vključno s skladnostjo in varnostjo, našim strankam zagotavljamo neprimerljivo raven gotovosti.
Zagotavljamo popolno preglednost in sledljivost vsake serije, ki smo jo izdelali, s čimer zagotavljamo, da imate vse, kar potrebujete za ustvarjanje obetavnih izdelkov s popolnim zaupanjem.

Pripravi se
Vas zanima sodelovanje z nami pri razvoju vaših prilagojenih izdelkov za fermentacijo? Preizkusiti morate naše storitve DeePPD™, kar pomeni poglobljen razvoj partnerstva izdelkov, ki deli priložnosti, ustvarjene skupaj z vami. Prepustite nam svoje ideje in koncepte!
Kontaktiraj nas














